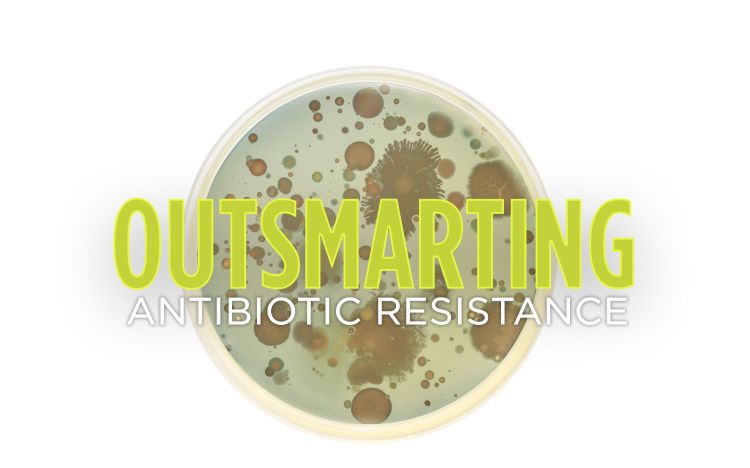
Outsmarting antibiotic resistance

Outsmarting antibiotic resistance
Spartan experts answer a global call to action to help ensure a healthy future for all.
For generations, society has relied on antibiotics to cure a number of illnesses and diseases, some of which are life-threatening. Today, however, there is concern that we are moving toward a time when the current supply of antibiotics is no longer useful. Becoming ill with an infection untreatable by modern medicine is terrifying. But that is likely preventable if society becomes more judicious about the use of these drugs and new antibiotics are brought to the marketplace.
Antimicrobial resistance, or drug resistance, is one of the most urgent health threats facing society. MSU is leading efforts to combat this serious problem, educate the public, work with industry and discover new solutions to attain optimal health for humans, animals and the environment.
To read the full article, visit MSU Today.



 Print
Print Email
Email




